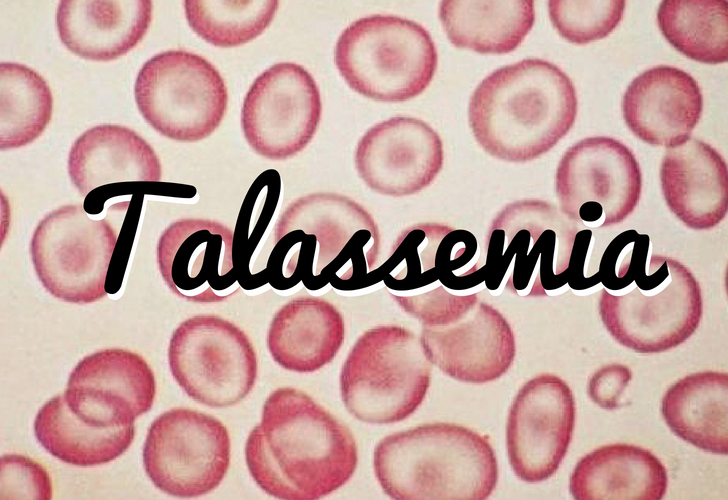

Talassemia: saiba o que é a doença e a importância do diagnóstico precoce
Neste domingo (8), Dia Internacional da Talassemia, um tipo de anemia hereditária, o Ministério da Saúde alerta para a importância da divulgação de informações sobre a doença, diagnóstico precoce e conscientização da população. O Sistema Único de Saúde (SUS) oferece o atendimento integral, desde o diagnóstico, monitoramento e o transplante de medula óssea quando indicado.
Segundo dados da Pasta, até abril deste ano, já foram registrados 930 pacientes com a doença no Brasil. Esse cadastro para os pacientes com talassemia é alimentado por 40 Serviços de Atenção Especializada em 24 estados. Entre os pacientes, cerca de 36% tem entre 20 e 39 anos. Ao todo, foram mapeados 137 Serviços de Atenção Especializada em Talassemias em todo o Brasil.
As talassemias são um grupo de doenças hereditárias crônicas que se caracterizam pela redução ou ausência de hemoglobina – substância dos glóbulos vermelhos do sangue responsável pelo transporte de oxigênio para todo o corpo. Pessoas acometidas pelo problema possuem uma variabilidade de sintomas, como anemia persistente, aparência pálida, aumento do baço, distúrbios cardíacos e endócrinos, atraso no crescimento e na maturação sexual, além de infecções recorrentes.
Em geral, o tratamento e acompanhamento desses pacientes é realizado pela Rede Nacional de Hematologia e Hemoterapia (Hemorrede), integrada pelos Hemocentros Coordenadores Estaduais e suas respectivas hemorredes regionais. Nos locais em que o tratamento não é oferecido na hemorrede, os estados instituem outros Serviços de Referência para esse tratamento especializado, necessário para evitar complicações da doença, que em casos mais graves pode implicar, inclusive, em transplantes de medula óssea.
O diagnóstico precoce da doença é fundamental. Os pacientes com o tipo de talassemia, com anemia grave, necessitam de transfusões de sangue de forma regular, geralmente a cada 20 dias, em média, para sempre, desde os primeiros dias de vida.
Talassemia no SUS
O Ministério da Saúde publicou materiais técnicos para padronizar o atendimento e orientar os profissionais de saúde no tratamento das pessoas com talassemia, como o Manual de Orientações para o Diagnóstico e Tratamento das Talassemias Beta, Caderneta da Pessoa com Talassemia e Folder Talassemias.
Além disso, a pasta está implantando o cadastro dos pacientes com talassemias dentro do Sistema Hemovida Web Hemoglobinopatias, instrumento de apoio na informatização dos serviços para a coleta de dados, importante ferramenta para monitoramento e avaliação dos casos.
Gustavo Frasão
Ministério da Saúde








